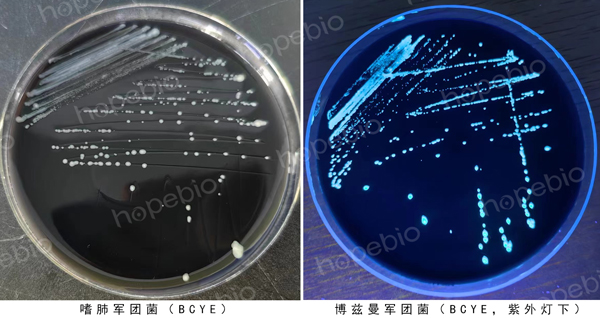
军团菌的活化常用BCYE平板

海博微信公众号
海博微信公众号
 海博天猫旗舰店
海博天猫旗舰店


 海博微信公众号
海博微信公众号
 海博天猫旗舰店
海博天猫旗舰店




一、军团菌简介
军团菌(Legionella)是自然界中广泛存在的条件致病菌,需氧革兰氏阴性杆菌,在20世纪70年代军人中爆发,被称为军团病,主要引起人的呼吸系统疾病,是一种胞内寄生菌。由于营养需求特殊,早期分离困难,在一般的培养基(如营养肉汤、TSB、脑心浸液肉汤等)上不生长,血平板上也不生长,现常用GVPC和BCYE进行分离培养。初代分离培养或活化通常要在BCYE平板上35-37℃培养3-10天,在含2.5%二氧化碳气体环境中更易培养成功,军团菌生长缓慢,菌落通常为灰白色,对半胱氨酸有依赖性,在半胱氨酸缺失的BCYE(BCYE-CYS)平板上不生长,这一特点常用来做军团菌的鉴定。军团菌常存在于空调、通风系统中,可存活数月之久,因此在公共卫生管理和检验中,常对空调送风系统进行军团菌的检测。
二、活化方法
培养基:军团菌的活化常用BCYE平板。
气体环境:BCYE培养基中含有ACES缓冲液和活性炭可使军团菌不需要在二氧化碳培养箱中也能正常生长,但初代分离和培养建议在含2.5%二氧化碳培养箱中。
操作方法:若菌种为冻干粉形式,按照说明书溶解后,可直接涂布或划线至BCYE平板上,若菌种为甘油冻存管形式,从冰箱中取出速融后,涂布或划线至BCYE平板上,35-37℃培养3-10天。
三、实验室常用保存方法
1.斜面保存法
将BCYE培养基制成斜面管,接种军团菌后培养至菌落生长良好,置于2-8℃可保存1-2个月或更长时间,若在表面覆盖无菌液体石蜡隔绝空气和减少水分蒸发可延长保存时间。
2.甘油冷冻保存法
可挑取培养好的军团菌菌苔至军团菌专用菌种保存管中制成约109CFU/mL的菌液,置于冰箱或液氮罐中冷冻保存,一般在-20℃可保存一年以上,在-70℃以下可保存两年以上。
注意事项:
1.钠离子对军团菌的生长有抑制作用,因此在配制BCYE或GVPC培养基时,要确保原料中尽可能除去钠离子,在进行培养基pH调整时,要使用氢氧化钾,不可使用氢氧化钠。
2.进行甘油冷冻法保存时,应使用军团菌专用的保存管(普通的菌种保存管一般含有钠离子,不利于军团菌的存活)。
相关产品:
注:本文属海博生物原创,未经允许不得转载。
| 相关文章: | ||



